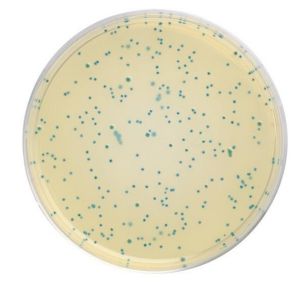
【

概述
 大腸菌群
大腸菌群大腸菌群指的是具有某些特性的一組與糞便污染有關的細菌,這些細菌在生化及血清學方面並非完全一致,一般認為該菌群細菌可包括大腸桿菌、枸椽酸桿菌、產氣克雷白氏菌和陰溝腸桿菌等。
大腸菌群是作為糞便污染指標菌提出來的,主要是以該菌群的檢出情況來表示食品中有否糞便污染。
大腸菌群數的高低,表明了糞便污染的程度,也反映了對人體健康危害性的大小。糞便是人類腸道排泄物,其中有健康人糞便,也有腸道患者或帶菌者的糞便,所以糞便內除一般正常細菌外,同時也會有一些腸道致病菌存在(如沙門氏菌、志賀氏菌等),因而食品中有糞便污染,則可以推測該食品中存在著腸道致病菌污染的可能性,潛伏著食物中毒和流行病的威脅,必須看作對人體健康具有潛在的危險性。
分布
大腸菌群分布較廣,在恆溫動物糞便和自然界廣泛存在。調查研究表明,大腸菌群細菌多存在於恆溫動物糞便、人類經常活動的場所以及有糞便污染的地方,人、畜糞便對外界環境的污染是大腸菌群在自然界存在的主要原因。糞便中多以典型大腸桿菌為主,而外界環境中則以大腸菌群其他型別較多。
檢驗方法
由於大腸菌群指的是具有某些特性的一組與糞便污染有關的細菌,即需氧及兼性厭氧、在37℃能分解乳糖產酸產氣的革蘭氏陰性無芽孢桿菌。因此大腸菌群的檢測一般都是按照它的定義進行。
中國採用的進出口食品大腸菌群檢測方法主要有國家標準和原國家商檢局制定的行業標準。兩個標準方法在檢測程式上略有不同。
國家標準
 檢驗流程
檢驗流程國家標準採用三步法,即乳糖發酵試驗、分離培養和證實試驗。
乳糖發酵試驗:樣品稀釋後,選擇三個稀釋度,每個稀釋度接種三管乳糖膽鹽發酵管。36±1℃培養48±2h,觀察是否產氣。
分離培養:將產氣發酵管培養物轉種於伊紅美藍瓊脂平板上,36±1℃培養18-24h,觀察菌落形態。
證實試驗:挑取平板上的可疑菌落,進行革蘭氏染色觀察。同時接種乳糖發酵管36±1℃培養24±2h,觀察產氣情況。
報告:根據證實為大腸桿菌陽性的管數,查MPN最大可能數表,報告每100mL(g)大腸菌群的MPN值。具體操作參見GB4789.3—94 《中華人民共和國國家標準 食品衛生微生物學檢驗 大腸菌群測定》
原國家商檢局制定的行業標準
原國家商檢局制定的行業標準採用美國FDA的標準方法,用於對出口食品中的大腸桿菌進行檢測。
推測試驗:樣品稀釋後,選擇三個稀釋度,每個稀釋度接種三管LST肉湯。36±1℃培養48±2h,觀察是否產氣。
證實試驗:將產氣管培養物接種煌綠乳糖膽鹽(BGLB)肉湯管中,36±1℃培養48±2h,觀察是否產氣。以BGLB產氣為陽性。查MPN表,報告1mL(g)樣品中大腸菌群的MPN值。
具體操作參見 SN0169—92 《中華人民共和國進出口商品檢驗行業標準 出口食品中大腸菌群、糞大腸菌群和大腸桿菌檢驗方法》
檢驗常用抑菌劑
大腸菌群
大腸菌群大腸菌群檢驗中常用的抑菌劑有膽鹽、十二烷基硫酸鈉、洗衣粉、煌綠、龍膽紫、孔雀綠等。抑菌劑的主要作用是抑制其他雜菌,特別是革蘭氏陽性菌的生長。
中國國家標準中乳糖膽鹽發酵管利用膽鹽作為抑菌劑,行業標準中LST肉湯利用十二烷基硫酸鈉作為抑菌劑,BGLB肉湯利用煌綠和膽鹽作為抑菌劑。
抑菌劑雖可抑制樣品中的一些雜菌,而有利於大腸菌群細菌的生長和挑選,但對大腸菌群中的某些菌株有時也產生一些抑制作用。有些抑菌劑用量甚微,稱量時稍有誤差,即可對抑菌作用產生影響,因此抑菌劑的添加應嚴格按照標準方法進行。
水質參數
作為水質參數的原因
 水質的快速測定
水質的快速測定①在人糞中大量存在,因此在為人糞所污染的水體中容易測到;
②檢驗方法比較簡便;
③對氯的抵抗力相似於致病的腸道細菌。可以認為:消滅了大腸菌群,致病腸道細菌也已消滅,水可供飲用。
水質檢驗
①發酵法。以不同量水樣接種於規定數目的含有不同量標準培養基的發酵管中,在37℃經24h培養後,如發酵管產酸產氣、顯微鏡檢驗又為革蘭氏陰性無芽孢桿菌,則為陽性反應。根據培養和陽性的發酵管數目,按統計學原理即可得出大腸菌群數(每升或每100mL中的個數)。
②濾膜法。水樣通過濾膜過濾,因膜的孔徑很小,大腸菌群截留在膜上。將濾膜移到遠藤氏培養基上,在37℃經24h培養後直接數典型菌落數,即得結果。由於濾膜要具有標準的孔徑,以及操作上所需的技術要求較難掌握,濾膜法的使用還不普遍。兩種方法所得結果不可比較。
1976年中國頒布的生活飲用水水質標準規定,每升水中大腸菌群不超過3個。
相關事件
2012年6月28日,廣州市工商局委託檢驗機構對市場上銷售的方便食品(不含速食麵)進行了抽檢,其中皇室核桃營養麥片與周氏牛奶加鈣即溶燕麥片因大腸菌群超標齊登“黑榜”。抽檢結果顯示,有14批次不合格產品表現為菌落總數、真菌和大腸菌群等微生物指標超標,該產品被要求立即下架。
專家表示,菌落總數、真菌、大腸菌群是衡量食品衛生狀況的重要微生物指標,如果大腸菌群嚴重超標,可能會引起腸道傳染病或食物中毒。
2012年10月19日,長沙市第三季度食品安全檢驗檢測情況新鮮出爐,第33個不合格名單原本是長沙肯德基有限公司阿波羅店的香辣雞腿堡。長沙市衛生局抽檢了8月29日批次的漢堡,發現大腸菌群含量為230MPN/100g,按照食安糕≤30MPN/100g的標準,此漢堡超標7倍多。

